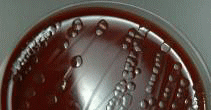
検査画像
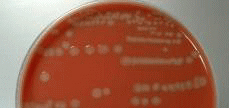
検査画像

臨床検査科
中央採血室
中央採血室は、各外来の採血および尿検査の受付、実施を行う場所です。
採血業務は臨床検査技師、看護師、事務職員で構成運営を行っています。
- 本人確認のため患者さんに名前をフルネームで言っていただいています。
- アルコール消毒によるアレルギーの有無を確認しています。
- 採血時に、痛み・しびれを感じた場合は我慢せずに担当者にお伝えください。
- 血管迷走神経反応(VVR)(採血への不安や緊張が引き金になってめまいや意識不明に襲われる)による転倒等がありますので、不安を感じたらベッドでの採血も行っています。担当者にお申し出ください。
- 採血業務は血管を針で傷つけますので、採血後5分間圧迫をお願いします。
- 尿を我慢できない方は、受付時にお申し出ください。
生化学検査室
生化学検査は各種体液(主に血液、尿)を比色分析法、電極法、HPLC(高速液体クロマトグラフィー)等で測定します。迅速性、正確性を要求される検査です。疾患の診断、治療、予防のために客観的情報を臨床に提供し、病態や病因の解明に役立てることを目的とします。主に肝機能、胆道機能、腎機能、膵機能検査を行っています。当科の基本方針の「真心と信頼」を大切に日々の業務にあたっています。
生化学検査項目についてはこちら
輸血検査室
1. 血液型検査
ABO式血液型
赤血球表面の抗原を検査するオモテ検査(抗A血清・抗B血清を使用)と血清に存在する抗体を検査するウラ検査(A1血球・B血球使用)で判定します。
| オモテ検査(赤血球側) | ウラ検査(血清側) | 血液型 | 日本人の割合 | ||
|---|---|---|---|---|---|
| 抗A | 抗B | A1血球 | B血球 | ||
| (+) | (-) | (-) | (+) | A | 40% |
| (-) | (+) | (+) | (-) | B | 20% |
| (-) | (-) | (+) | (+) | O | 30% |
| (+) | (+) | (-) | (-) | AB | 10% |
(+)は凝集、(-)は非凝集を示す。
Rh式血液型
C,c,D,E,eの5つの抗原がありますが、通常輸血の際に一番重要なD抗原の有無(抗D血清を使用)で判定します。D抗原が存在する場合をRhD陽性、D抗原が存在しない場合をRhD陰性と判定します。
2. 不規則抗体検査
不規則抗体検査はABO血液型以外の赤血球抗原に対する抗体を調べる検査です。不規則抗体には輸血歴や妊娠歴などのある人に見られる免疫抗体と、何ら免疫刺激のない人に見られる自然抗体があります。
不規則抗体の有無を事前に確認することは、安全な輸血や適合輸血の確保、血液型不適合による新生児溶血性疾患の予知と対策に重要な検査となります。
3. 交差適合試験
ABO式とRh式の血液型が一致した血液を輸血したとしても、そのまま輸血を行うと輸血副作用(溶血性など)を起こす可能性があります。それを防止するため、輸血前に血液製剤と患者様の血液が適合するかどうかを調べる検査です。
4. 輸血用血液製剤の種類
| 照射赤血球液 (Ir-RBC-LR)  |
新鮮凍結血漿 (FFP-LR)  |
照射血小板 (Ir-PC-LR)  |
5. 自己血輸血
自己血輸血は手術など輸血が必要になると予測される際に、あらかじめ採血し貯めておいた患者様の血液を輸血する方法で、他人の血液を輸血した時に起こる可能性のある輸血副作用を防止することができる輸血方法です。
免疫血清検査室
免疫血清学検査とは、抗原抗体反応の原理を応用した各種方法を用い、ヴィルスや細菌等の病原菌に感染した時の生体の防御反応(免疫反応)で出現する抗体の抗体価を測定し、病態の判定に役立てます。
1. 感染症検査
細菌やウイルス(抗原)に感染すると、その抗原が元になり体内の免疫機能により、血液中に抗体が産生されます。抗体とは、抗原の刺激により体内で作られ、その抗原と特異的に結合する蛋白です。血液中の抗原や抗体を測定することにより細菌やウイルスに感染したかどうかを確認することができます。
当検査室では梅毒・肝炎ウイルス・HIV・HTLV-1・マイコプラズマなどの検査を行っています。
HBs抗原
CLIA法 基準値 (-)<0.05mIU/ml
(+)の場合、現在B型肝炎ウイルスに感染していることを示す。
HCV抗体
CLIA法 基準値 (-)<1.0S/CO
(+)の場合、現在または過去のウイルス感染を示す。
2. 腫瘍マーカー検査
体内に炎症や腫瘍ができると、血液中に特殊な蛋白や酵素が異常に高値となることがあります。腫瘍に関連が深く、免疫学的検査で検出される物質を腫瘍マーカーと呼びます。臓器ごとに関連性があり、診断、治療効果判定、経過観察に使用されています。
当検査室ではCEA・AFD・CA19-9・CA125・T-PSA・F-PSAなどの検査を行っています。
CEA
CLIA法 基準値 <5.0ng/ml
消化器系癌の腫瘍マーカー。他のマーカーと組み合わせて癌の診断、治療効果、経過観察に用いられる。
AFP
CLIA法 基準値 <13.4ng/ml
肝臓癌の腫瘍マーカー。癌の診断、治療効果、経過観察に用いられる。
CA19-9
CLIA法 基準値 <37U/ml
消化器系癌の腫瘍マーカー。特に膵臓癌に特異性が高い。癌の診断、治療効果、経過観察に用いられる。
3. 内分泌(ホルモン)検査
ホルモンとは、体の内分泌腺から血液中に分泌される物質のことを言います。分泌されたホルモンの多くは、血流にのって離れた器官の細胞に作用します。ホルモンの作用はさまざまで、血糖や血圧をコントロールするホルモン、代謝に関するホルモン、生殖に関するホルモンなどがあり、これらを測定し内分泌疾患の診断の補助をしています。
当検査室ではTSH・FT3・FT4・インスリン・HCGなどの検査を行っています。
TSH(甲状腺刺激ホルモン)
CLIA法 基準値 0.35~4.94μIU/ml
脳下垂体から分泌され甲状腺ホルモン(T3,T4)の産生を調整する。主に甲状腺機能障害のスクリー二ング検査に用いられる。
FT3,FT4(甲状腺ホルモン)
CLIA法 基準値 FT3 1.71~3.71pg/ml FT4 0.70~1.48ng/ml
甲状腺ホルモンにはトリヨードサイロニン(T3)、サイロキシン(T4)の2種類がある。血中に遊離したFT3,FT4を測定し甲状腺機能障害のスクリー二ング検査に用いられる。
4. 血漿蛋白、自己抗体関連検査
抗原抗体反応(免疫反応)を利用し、感染症・炎症・自己免疫疾患の検査を行っています。当検査室ではCRP・RF・ASO・IgG・IgA・IgM・C3・C4などの検査を行っています。
血液検査室
体内の血液中の赤血球、白血球、血小板等の算定や分類によって、貧血や血液疾患の病態チェックが出ます。血液凝固検査は血小板や血奨成分の凝固に関する情報が得られ、出血、止血等の治療に役立ちます。骨髄検査は胸骨や腸骨の骨髄から貧血や白血病等の精査をすることが出来ます。
1. 形態検査(抹梢血液一般検査)
血液中の赤血球、白血球、血小板などの血球算定や分類をする検査。貧血や白血病などの血液疾患の病態をチェックすることができます。
2. 凝固検査(凝固・線溶検査)
血小板や血漿成分の凝固に関する情報を得る検査。この凝固検査で得られる情報により血栓治療効果をみたり、出血や止血などの病態チェックや治療に役立ちます。
3. 骨髄検査
胸骨や腸骨から骨髄液を採取し、貧血や白血病などの血液疾患の精査をする検査。
白血病診断には絶対に必要な検査です。
一般検査室
尿から細胞を集めて検鏡したり、蛋白、糖などを定量的に分析する事により、多くの病気の情報が得られます。便からは消化器系の出血の有無、寄生虫卵の検出、その他、髄液検査、胸水、腹水の検査、精液検査、薬物中毒の検査を行っています。
1. 尿検査
腎臓は血液から老廃物や余分な水分などのろ過、再吸収、分泌により体液の恒常性の維持をしています。
このように、1日約1500ml排泄される尿の元は血液なので、腎臓・肝臓・すい臓などの体の様々な情報が尿検査から得られます。当院尿定性検査項目は、尿色調・尿比重・尿蛋白・尿糖・尿ケトン体・尿潜血・尿中ウロビリノーゲン・尿中ビリルビン、尿白血球反応を実施しており、尿の細胞を集めて顕微鏡で見る尿沈渣の検査をすると、さらに詳しい腎臓の状態や、尿路感染症、結石、癌などの診断に役立ちます。
2. 糞便検査
主に大腸がんのスクリーニングや消化器の出血を調べるのに検査をします。大腸にできる癌はポリープ状になることも多く、大腸を便が通過するときにポリープをこすっていきます。ポリープはこすれるとその部分が擦り切れてほんの少量だけ出血し便の表面に付着します。見た目には血液がついているのがわかりませんが、当院検査室で実施しています便中ヒトヘモグロビン測定は微量のヒトヘモグロビンでも検出することが出来ます。
自己採便をするときは、便の表面をこするように少量採取し採便容器には多量に便を詰め込まないことがコツです。
3. 寄生虫検査
近年、海外旅行者の増加や無農薬野菜を良く食べるようになったため寄生虫症にかかる方が増えてきています。
寄生虫と聞くとサナダムシを連想される方が多いかと思いますが、他には蚊が媒介し高熱が出るマラリア、おしりにテープを張って検査をする蟯虫(ギョウチュウ)、新鮮なイカやサバを刺身を食べて感染することすごくお腹が痛くなるアニサキス、きちんと洗浄消毒をしていないコンタクトレンズを使用していると角膜炎の原因となるアカントアメーバ、毛じらみ、ノミ、ダニなども聞いたことのある寄生虫かと思います。
海外旅行や生食を好む方は寄生虫に感染する機会が多いので、体がおかしいと思いましたら医療機関へ受診をおすすめします。
4. 精液検査
男性の精液の量・数・元気な精子がどれ位いるかを調べる運動率・形の変な精子がどれ位いるかを調べる奇形率などの検査を行います。
精子は生き物なので取り扱いがとてもデリケートで温度や採取時間に注意を払って検査をしています。検査結果の持つ重要性がとても大きい検査なのでとても大事に行う検査のうちの一つです。
5. 髄液検査
脳脊髄液(髄液と略します)は脳や脊髄のまわりを満たしていて衝撃、薬物、細菌やウイルスなどから脳や脊髄を守っています。
その髄液は通常であれば無色透明できれいですが、脳や脊髄に傷ができたり、細菌やウイルスに感染したり、出血をしたりすると髄液が濁ったり、色がついたりさまざまな変化が見られます。検査室では採取してきた髄液を白血球の数、量、濁りはないか、糖やたんぱく質はどれ位あるのかを検査します。脳のまわりにある水をとるので頭に直接針を刺すと思いがちですが、実際は背中を丸めて腰の辺りに針を刺して採取することが多いそうですのでご安心を。
細菌検査室
細菌検査
感染症は細菌、真菌、ウイルス、寄生虫などさまざまな病原体によって引き起こされます。
細菌検査室は、感染症が疑われる患者様の検査材料(喀痰、尿、便、血液、髄液等)から細菌や真菌を検出し、その菌がどの種類の薬(抗生物質)が効くかを調べます。
1. 塗抹検査(グラム染色・抗酸菌染色)
検査材料を染色し、顕微鏡にて観察します。原因となる細菌や真菌(写真参照)を推定します。
2. 培養・同定検査
培養検査は、培地に検査材料を塗り、肉眼で菌を観察できる状態にします。
同定検査は、発育してきた菌(写真参照)の性状を調べ、菌名を決定します。
3. 薬剤感受性試験
検出された原因菌に、どの種類の薬(抗生物質)が効くかを調べます。
4. ご自宅にて細菌検査用としての検査材料の採り方
(1)喀痰の採取・保管
早朝、起きた直後に採取するのが最適とされています。
口の中は細菌などの微生物がたくさんいますので、水道水で2~3回うがいをしてから採取してください。
喀痰は強い咳と共に下気道から排出されたものがよく、鼻汁や唾液の混入はできるだけ避けてください。
紙などに包まず、直接容器に喀出してください。冷蔵庫(4℃)にて保管し、病院までお持ちください。
(2)便の採取・保管
成人の場合、親指の頭程度の量を採取し、採便容器に入れ、フタを閉め、ビニール袋に入れてください。
水様便や下痢便の場合は、市販の紙コップ等で採取してから、採便容器に入れてください。
乳幼児でオムツを使用している場合は、そのままビニール袋に入れてください。
採取後は、できるだけ早く病院までお持ちください。当日お持ちになれない場合は冷所にて保管してください。
病理検査室
病理組織学的検査の対象となるのは、手術および試験切除・内視鏡検査で得られた生体組織と穿刺および塗抹等で得られた細胞です。その目的は病変の性質、程度、範囲等を判定し、疾患の最終診断に直結すると共に、適切な治療方針を確定することです。
このように、病理組織学的検査は患者さんの生命をも左右する重要な検査です。
病理検査室
病理検査室は内視鏡室とエコー室に隣接し、病理検査を迅速に行える環境下にあります。スタッフは病理医、臨床検査技師、細胞検査士、事務職員で構成され、これらスタッフの連携にて運営されています。
病理検査とは
病理検査(Pathological examination)とは、病気(疾患)の診断や原因(病因)の究明・予後の推定・治療効果の判定を目的として、手術または検査の目的で採取された臓器、組織、細胞などの形態を顕微鏡下で観察し、診断を行うことである。
病理検査の種類
1)病理組織検査 2)細胞診検査 3)病理解剖に大別されます。
1)病理組織検査
生検あるいは手術で採取された組織からプレパラート標本(顕微鏡で観察するためのガラス標本)を作製します。プレパラート標本と は、病変部から採取した臓器や組織の一部を2~3μm(1μmは1mmの1000分の1)程度に薄く切り、スライドガラスに貼り付け、見やすく色づけして構造と形態を観察するための標本です。この標本を病理医が顕微鏡で観察し、腫瘍の場合は、腫瘍の良悪性、腫瘍の種類、腫瘍の範囲、浸潤の程度を診断します。手術中の迅速診断検査では、検体を瞬時に凍結させて標本を作製し、約10分程度で病変部の診断や切除範囲の判定を行います。
組織診業務の流れ
- 検体提出:
内視鏡検査や外来等で採取された病変部の小さな組織はホルマリンという液に浸されて提出されます。手術で摘出された胃・大腸・肺などの大きな組織は検査室内にあるホルマリンの入った大きな容器で一定時間浸して固定(組織の形態が変化するのを防止)します。 - 検体受付:
検体と依頼伝票を一緒に提出していただきます。双方に同一の検査番号をつけ病理システムにて受付・台帳管理をします。 - ブロック作製:
小さな組織は専用容器(包埋カセット)に入れ、大きな組織は固定完了後、病理医と検査技師によって適切な大きさに切り分け、必要箇所を包埋カセットに入れ、専用機器(脱水装置)を使い、最後はパラフィンというロウを充填して、パラフィンブロックが完成します。 - 薄切:
固められたブロックをミクロトームという機器を用いて厚さ2~3μm程度に薄く切り、スライドガラスに貼り付けます。 - 染色:
細胞の核と細胞質を染め分けます。染め上がった標本の表面をカバーガラスで保護(封入)し、標本が完成します。 - 鏡検・結果報告:
出来上がった標本を病理医が顕微鏡で観察し、組織診断名(病名)と所見を報告します。
2)細胞診検査
病理組織検査が身体から組織の一部を採取した材料で検査するに対して、細胞診は身体に影響(浸襲性)の少ない検査です。尿、喀痰、胸水、腹水等の中に含まれている細胞を集めたり、病変部を擦過または針で吸引して得た材料からプレパラート標本を作製し、細胞レベルで「がん細胞」を検索する検査です。プレパラート標本を顕微鏡で観察し、正常な細胞の中から「がん細胞」を探し出すのが、細胞検査士です。細胞検査士が見つけ出した「がん細胞」や「疑わしい細胞」を最終判定するのが、病理医や細胞診専門医です。
検体の種類
- 婦人科の子宮頸部・子宮体部・膣壁・外陰部や気管支鏡下で気管支表面などから綿棒やブラシで擦って採取した擦過標本
- 甲状腺・乳腺・唾液腺・肝臓・リンパ節・皮下などにできた腫瘍に針を刺して細胞を吸引した標本。
- 喀痰、尿、胸水、腹水、心嚢液、髄液、胆汁、膵液、関節液などの液状検体全ての標本。
細胞診業務の流れ
- 検体採取:
まずは細胞の採取から始まります。患者様ご自身に採取していただく場合と医師により採取する場合があります。
検体によっては細胞検査士が採取時に立会いその場でスライドガラスに塗沫(塗りつけ)します。 - 検体受付:
検体と依頼伝票を一緒に提出していただきます。双方に同一の検査番号をつけ病理システムにて受付台帳管理をします。 - 標本作製:
採取された検体をスライドガラスに塗沫(必要な細胞を塗りつける)します。 - 固定:
目的に応じた方法で細胞を固定(細胞の形態が変わらないように)します。 - 染色:
細胞の核と細胞質を染め分けます。染め上がった標本の表面をカバーガラスで保護(封入)し、標本が完成します。 - 鏡検:
出来上がった標本全面を細胞検査士が顕微鏡で観察します。 - 結果報告:
細胞検査士と指導医でディスカッションし、推定組織診断名(病名)、細胞所見をクラス分類(1,2,3,4,5)して報告します
3)病理解剖
病死された患者さんの遺体について、ご遺族の承諾を得て、主・副病変、合併症、直接死因などの確定、臨床診断の評価、臨床症状・経過・検査成績などと各臓器の形態学的所見との関連、治療効果の判定、臨床上の疑問点の解明など、その疾患の本態を明らかにするために行います。そして、今後における病気の予防や診断・治療に役立てていきます。病理解剖では、外からわかりにくいように切開し、診断に必要な臓器を取り出し、2~3時間ほどで終了します。病理解剖の肉眼所見は、解剖を行った病理医から主治医へと報告され、ご遺族に説明されます。なお、顕微鏡所見を含めた最終診断には2~3週間の時間が必要です。病理解剖の結果が蓄積される事によって、他の方法では得がたい医学の進歩への貢献が期待されます。病理解剖はある意味で個人がなしうる社会への最後の貢献といえます。
補足:(社)日本病理学会では、全国の病理解剖の情報を集めて『日本病理剖検輯報』を毎年出版することによって、世界一正確な死因統計を提供し、国民の健康・福祉に貢献しています。
生理機能検査室
生理機能検査とは生体現象を電気的、物理的にとらえ記録する検査です。心電図から心筋梗塞、不整脈、虚血性心疾患等の情報が、脳波検査ではてんかんや脳機能障害等の情報が得られます。肺機能検査は、呼吸機能障害の性質、機構、程度を知ることが出来ます。心臓超音波検査では、心臓の形態、動態、血流の情報が得られます。誘発脳波検査には聴覚、視覚、体制感覚等の検査があります。その他、動脈硬化の検査(ABI、皮膚灌流圧SPP)血管系超音波検査、筋電図、誘発筋電図等を行っています。
生理機能検査室には心電図室、心臓超音波及び血管超音波室、運動負荷検査室、肺機能室、脳波筋電図室があります。
現在、生理機能検査室には日本超音波医学会、日本超音波検査学会、心エコー図学会、日本血流血管学会、等に在籍するスタッフ11名が検査を実施しております。その内、超音波検査士(循環器、腹部、体表血管)、血管診療技師、等の学会認定資格を有する者は7名います。
12誘導心電図
心臓の拍動が繰り返されるごとに起電力が生じます、それにより身体内に電流が流れ、電位の分布が発生します。この心臓の活動によって生ずる電位変化を、身体表面の適切な部位から記録し波形として表したものが心電図です。不整脈や虚血性心疾患等の情報が得られます。
運動負荷心電図 トレッドミル負荷
運動をして心臓に負荷をかけた時の心電図や血圧を測定する検査で、不整脈、虚血性心疾患の診断、心機能評価、治療効果の判定、予後の判定が目的です。
ホルター24hr心電図
ホルター心電図検査とは、日常生活中の心電図を長時間にわたって記録・解析する検査です。これは、日常生活の行動で心電図がどのように変化するか、また何等かの症状(動悸、めまい、胸痛など)がある時の心電図が、症状のない時の心電図に比べてどのように違うかなどについて調べるものです。
携帯型自動血圧連続測定装置 ABPM
血圧は飲酒、喫煙、部屋の温度、痛みなどによって容易に変動します。ABPMは、日常生活中の血圧を24時間にわたって記録し、デ-タを解析することによって、血圧の変化(日内変動)を知り、抗圧剤の効果判定等に役立てる検査です。
携帯型心電図記録装置
小型心電図記録装置を1ヶ月程度携帯していただき、患者さんご自身に発作時の心電図を記録してただくものです。症状が出た時に心電図を記録できる利点があります。
肺機能検査
呼吸機能障害の性質、機構、程度を知る為の検査です。診断、病勢判定、予後の判定などの目的で行う検査です。検査項目としてはVC(肺活量・肺気量分画)、FVC(努力性肺活量・フローボリューム)、MVV(分時最大換気量)、FRC(機能的残気量)、MV(分時換気量)DLCo(拡散能力)、CV(クロージングボリューム)があります。
脳波検査
脳波は脳の電気的活動を記録したものです。頭皮上から誘導したものが一般的に言われる脳波であり、その他に手術中に頭蓋骨下の大脳表面からとる皮質脳波、脳実質内に電極を直接挿入して記録する深部脳波等もあります。正常人から記録した脳波はその意識レベルに応じてリズミカルな波形として認められますが、てんかん、脳腫瘍、及び精神障害等の脳神経系疾患を有する場合では健常人と異なった波形を示します。健常人でも意識水準の相違、睡眠時、および薬物服用時には安静時と異なった波形を呈します。このように脳波は脳の機能状態の一面を反映することから脳波検査は脳神経系疾患の診断に適応されています。
誘発脳波
誘発脳波には聴性感覚誘発電位(ABR)、体性感覚誘発電位(SEP)、視覚誘発電位(VEP)等があり、それぞれの感覚刺激により神経経路の機能や異常を調べる検査です。
誘発筋電図
誘発筋電図には運動神経伝道速度(MCV)、知覚神経伝道速度(SCV)、顔面神経誘発電位(ENoG)等があり、電気刺激により末梢神経障害の程度を調べる検査です。
心臓超音波(心エコー)検査
心臓超音波検査は断層法、ドプラ法、Mモード法を用いることにより心臓の形態、動態診断はもちろん、血流情報や心機能評価が可能なため、循環器領域においては必須の検査法となっています。
頚動脈エコー検査
近年、虚血性心疾患や脳血管疾患など動脈硬化が深く関与している疾患は増加傾向にあり、動脈硬化の評価は、その予防的見地からも重要です。これまでの病理学的、臨床的検討から、頚動脈病変の存在が全身の動脈硬化の指標となり、脳卒中や虚血性心疾患の重要な危険因子になることが明らかになっています。頚動脈は粥状硬化の好発部位であり、その観察は全身血管の動脈硬化の評価に最適です。
下肢上肢の動脈エコー検査
食生活の欧米化による生活習慣病や高齢化による動脈硬化性疾患の罹患率は増加しています。中でも下肢上肢動脈の血管疾患は増加しています。急性動脈閉塞、動脈解離、仮性動脈瘤等の診断に有用な検査です。
下肢上肢の静脈エコー検査
生活習慣病や高齢化による下肢上肢静脈の血管疾患は増加しています。肺塞栓症等の重篤な合併症に関連する深部静脈血栓症等の診断に有用な検査です。
SPP(皮膚灌流圧)
局所の皮膚微小循環の灌流量を評価する検査です。糖尿病性足病変や石灰化症例の重症度評価や難治性潰瘍の治癒予測、PTA、下肢バイパス術のモニタリング等に用いられます。
ABI(足関節上腕血圧比)、PWV(脈波伝播速度)
ABIは足首と上腕の血圧を同時に測定しその比率を求めたものです。PWVは心臓の拍動(脈波)が動脈を通じて手や足まで届く速度の事です。潜在的な末梢動脈疾患(PAD)など動脈硬化の程度や血管障害を調べる検査です。
AABR(新生児聴力検査)
在胎34週に相当する児から生後6ヶ月までの児の聴力をスクリーニングする検査です。
その他
臨床研究に関するオプトアウトについて
当科では、東邦大学医療センター佐倉病院が主体となって行われている臨床研究、「輸血関連検査異常反応時における赤血球抗原比率、不規則抗体の免疫グロブリンクラス、単球貪食試験の検討」について、研究協力を行っています。研究のために自分のデータが使用されることを望まれない方は、担当医までお知らせください。
品質保証施設認証制度施設基準 合格について
この度、公益社団法人 日本臨床検査標準協議会と一般社団法人 日本臨床衛生検査技師会が協働で行う認証制度を受審し「品質保証施設認証施設」として施設基準に合格致しました。(R7.6.1)
「品質保証施設」とは・・・
「精度保証施設」として、臨床検査の精度が十分保証されていると評価できる施設に対して認証を示す制度として発展してきたものです。医療法改正(平成29年法律第57号)後に、医療法等の一部を改正する法律の趣意に基づき、臨床検査の精度(価値)向上をさらに図る観点から、臨床検査(検体検査/生理機能検査)の分析に於いて、検査値の確認を対象とした精度管理の範囲から、検体採取を含め検査工程の全てを範囲とした品質管理に対して保証する制度にバージョンアップされたものです。
当院は、長年に亘り「精度保証施設」として登録を受けてきましたが、新制度になりこの度令和7年度の申請に於いて、9部門(臨床化学、血液、一般、免疫、微生物、輸血、細胞、生理、病理)全てに於いて基準をクリアし認証が認められました。
臨床検査科は今後も、臨床検査の全ての工程に於いて、そこに関連する人材資源の確保教育に於いても、精度管理事業、及び標準化事業に積極的に参加し、当院における検査データが常に標準化に基づいたものであり、かつその精度が是正・改善を通じて十分評価されるよう、より一層精進してまいります。